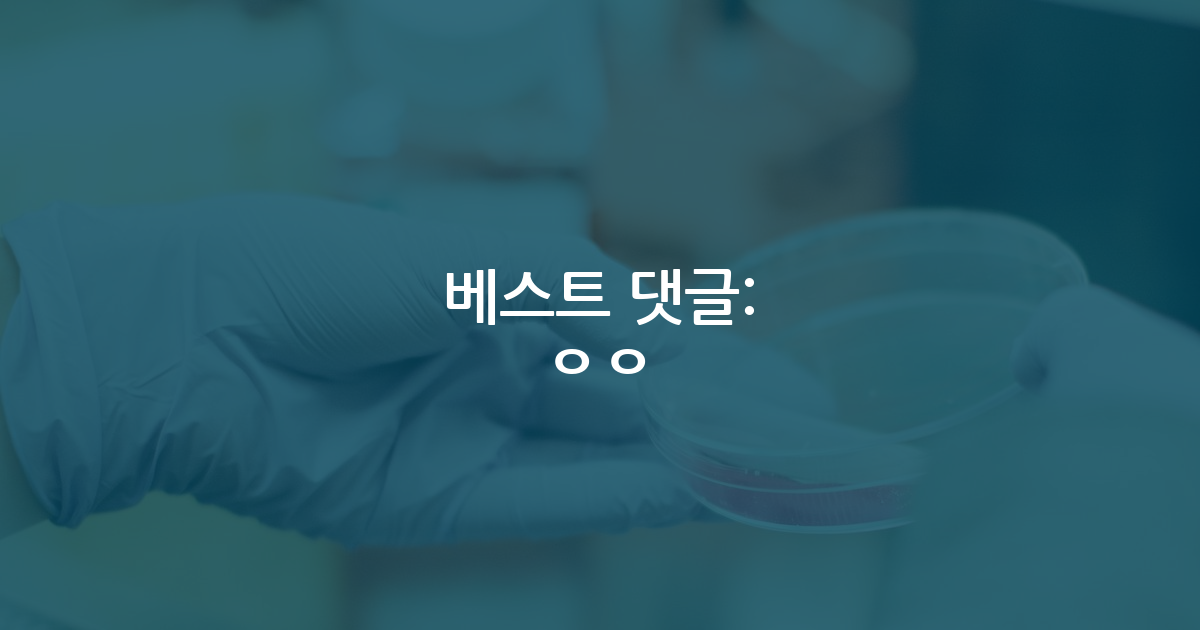

카카오 계정과 연동하여 게시글에 달린
댓글 알람, 소식등을 빠르게 받아보세요
가장 핫한 댓글은?
- 서울대 카이스트 이외에 아무런 의미 없습니다.
미국대학 커미티에서 보는 한국 대학의 레벨
7 - 다들 경험으로 아는것 같습니다. 저는 카이스트 졸업해서 미국넘어왔는데, 젊은 백인교수 PI는 우선 우리분야에서 유명한 카이스트교수가 있어서 알뿐더러, 자화자찬하기는 그렇지만 PI랑 있는동안 제가 꽤좋은모습 보여줘서 + 옆랩 친한교수도 한국인학생 좋아해서 한국인, 그중에서도 카이스트를 좋아합니다. 아예 제거 선물로준 카이스트 로고스티커를 본인 컴퓨터에 붙이고다닙니다.
예전에 오피스옆에서 엄청 늙은 교수님 뵐때 어디출신이냐해서 한국이라 하니, 갑자기 한국인이 중국인 네명보다 낫다면서 본인 졸업생중 한국인많앗는데 다 너무잘햇다고 말해서 제가 더 당황했던 기억도 있습니다.
반대로 안좋은 한국인학생 뽑고 악담하는 교수도 있겠죠.
여튼 한국학교는 역사가 길지않기에 다들 본인분야 유명한교수 유무, 본인 예전동료 혹은 제자들중 출신들을 보고 특정학교에 대한 인식이 생기는건 어쩔수없습니다.
그러니 미국나오셔서 좋은모습 보여주면 본인도 잘되지만 후배들한테도 잘되는 길임을 명심하시길.. 작은 인식들이 모여서 일반화가 되니
미국대학 커미티에서 보는 한국 대학의 레벨
7 - 현직 교수고 김박사넷에서 댓글 처음 남겨보는데 그냥 석사학위도 없이 나가세요
뭐 박사학위 맡겨놓은거마냥 하면서 내가 선택해서 석사만 하는거야 식의 논리를 펼치는지 ㅎㅎ
당신같은 박사 교수도 원치 않을겁니다
교수한테 막말듣고 석박통합에서 석사로 전환함
95 - 속 시원 ㅋㅋㅋ
제안서를 문장 하나에 4-5줄글로 작성하는 정신나간 교수들
12 - 일 안해보고 제안서도 안써본 세대들이 교수되니깐 이꼴이 나는 중임ㅋㅋㅋㅋㅋ
제안서를 문장 하나에 4-5줄글로 작성하는 정신나간 교수들
6 - 스카이서성한 >> 카포
지금은 지방소멸시대입니다.
90년대에 유행한 서카포
현재는 스카이서성한 입니다.
SKP 박사는 SSH 대비 1년 늦게 받아도 이득일까요?
7 - 당연히 가야지요. 초반에 사람들과 빨리 안면트고 적응하려는 노력도 비즈니스이고 스킬입니다. 이런 상황에서 안가면 교수님께 별로 좋게 보이진 않을꺼예요. (저희 그룹에 비슷한 케이스가 있었어서요.)
워크샵 가는게 좋을까요?
8 - 제 동기이자 랩장도 딱 저러는데 저런 인간군상은 어디에나 존재하나 봅니다..ㅋㅋ 무능력+질투+남욕+강약약강
연구실 동기 때문에 힘들어요..
8 - 아니 왜 그런 뻘짓을… 자소서에는 뭐라고 설명하게요? 무슨 바이오 전공인데 컴싸로 학사 다시 따는 식으로 전공을 아예 전혀 관련 없는 과로 바꾸는 식이면 하고 싶은게 생겨서 어쩌고 이렇게 얘기라도 만들 수 있지
그리고 이미 140 학점 들었으면 편입해서 세탁(?)해도 어차피 해외대학원 지원서에 전적대 성적표 내야합니다.
턱걸이라도 GPA 3.0/4.0 넘으면 차라리 자대 석사 해서 석사 학점 + 실적으로 만회하는게 나아요.
전공, 계획을 안써줘서 이 이상 자세히 조언 못해주는데 지금 적어놓은 것만 봐서는 ㄹㅇ 뻘짓하는거라 그닥…
학점이 낮아서 다운그레이드로 편입하는 경우도 있나요?
7 - 난 저게 더 좋은데? 개조식은 뭔가 그냥 팩트만 나열만 한 느낌. 설득력이 전혀 없음.
제안서를 문장 하나에 4-5줄글로 작성하는 정신나간 교수들
7 - 개조식이 이해하기에는 편하지. 그런데 그건 내맘대로 이해할 때의 얘기야. 문장과 문장이 연결되는 부분을 내맘대로 이해하기 때문에, 곰곰히 생각하면 정말 그런 의미로 쓴 것일까 하는 의문이 들 때가 많지. 정확한 의미 전달 관점에서 개조식은 정말 위험한 글쓰기야.
제안서를 문장 하나에 4-5줄글로 작성하는 정신나간 교수들
5 - 발표자료, ppt라면 개조식을 사용하는게 맞다고 봐요
아무래도 한 페이지 보여주는 짧은 시간동안 발표하는 사람의 말을 따라가랴, 그림 확인하랴, 거기에 장황하게 설명까지 있으면 도저히 읽을 여력이 없으니까요
하지만 제안서라면 조금 이야기가 다르지 않나 생각해요
물론 제안서를 심사하는 심사위원의 입장에서라면 개조식이 좋게 느껴질 수는 있긴하죠
심사위원 분들 많은 제안서를 읽는 만큼, 다양한 분야에 대한 기초지식도 어느정도는 깔려있기에, 구구절절 설명하는 것이 불필요할 수도 있죠
그런 상황에서 심사해야할 글이 한두개인 것도 아니고, 만연체를 다 읽어낼 시간이 부족하긴 하니까요
하지만, 글을 작성하는 사람의 입장에서는 또 그렇지만도 않아요. 읽는 심사위원이 내 연구를 잘 알 것이라는 믿음 만으로, 개조식으로 핵심 내용만 작성하라는 것은 조금 무리가 있음
솔직하게 말해서, 모든 AI 관련 연구를 하시는 분들이 전부 본인 연구를 개조식으로 작성해서 가져오면 본문의 글과 큰 차별점을 느낄 수가 없을걸요?
자기가 하는 연구가 왜 필요한지, 다른 연구와 무엇이 다른지, 심사위원이 왜 내 연구를 채택해야하는지 설득을 하기에는 개조식은 많는 부족함이 있다는 말입니다.
물론 읽는 사람을 배려하지 않는 정보를 꽉꽉 채우기만 한 글은 바람직하진 않긴하죠
정보의 전달과 가독성 두 마리의 토끼를 다 챙겨갈 수 있는 절묘한 밸런스를, 제안서를 작성하시는 분들은 고민을 더 해야할 것 같아요
하지만, 그래도 개조식으로 작성해서 제출하라라는 말은 제안서를 작성하는 사람들의 절실한 마음은 무시한채, 본인들의 업무 편의성만 고려한 의견인 것 같기는 해요
제안서를 문장 하나에 4-5줄글로 작성하는 정신나간 교수들
5 - 건방진 의견. 제안서 마다 성격이 다르고, 기본적으로 깔끔한 글쓰기가 바탕이 되어야하는건 맞지만 개조식이 필요한 섹션이 있고 아닌 섹션이 있음.
제안서를 문장 하나에 4-5줄글로 작성하는 정신나간 교수들
6
학부연구생 짤당했는데
2025.11.30
학계 뜹니다. 김GPT 60 14 13143-
23 23 26082 -
50 10 20011 -
20 16 5626 -
43 17 7494
학부 직장인 연구원 김GPT 0 0 464
학부연구생(인턴) 발표 김GPT 1 10 3987
의대 자퇴생 공대 휴학생 김GPT 33 19 3960
넋두리.. 김GPT 8 8 2519-
173 30 48638 -
98 88 71935
연구실을 옮기는 것에 대하여 명예의전당 161 33 28428
베스트 최신 글
- 워크샵 가는게 좋을까요?
2691 - 석사1 학기때 작성한 과제 제안서 구현이 힘들거같습니다.
3298 - 대학원 재수에 대해 어떻게 생각하시나요?
4453 - 생각보다..연구가 재미가 없습니다..
4901 - 여기 김학사넷 아니고 김박사넷이다. 학부 입결, 특히 서성한 ist 싸움 어휴
4651 - SPK 물리학과입니다. 군 해결 시기와 방법 및 유학 조언 구합니다.
3237 - 학부 2학년 nature 자매지 공동저자 되는걸까요?
4144 - 석박 통합 6년차에 교수님이 나가라고 하시네요
45143 - 석사 포기했습니다.
9593 - 한밤중 지도교수님의 손절하겠다는 톡
9871
베스트 최신 글
🔥 시선집중 핫한 인기글
- 첫 논문 작성할 때 레퍼런스 정리 꿀팁 (+a)
249 - 영과고에서 선호도는 설>>카>>>>>>포 임
43 - 교수한테 막말듣고 석박통합에서 석사로 전환함
109 - 개 미 친 싸 이 코 같 은 리 뷰 어 새 X
181 - 살려주세요...
31 - 석사 포기했습니다.
43 - 여기 김학사넷 아니고 김박사넷이다. 학부 입결, 특히 서성한 ist 싸움 어휴
40 - 생각보다..연구가 재미가 없습니다..
11 - 석박 통합 6년차에 교수님이 나가라고 하시네요
54 - 연구실 동기 때문에 힘들어요..
11 - 석사1 학기때 작성한 과제 제안서 구현이 힘들거같습니다.
6 - 학점이 낮아서 다운그레이드로 편입하는 경우도 있나요?
5 - 컨택용 연구계획서를 어느 수준으로 작성해야 할까요?
3
최근 댓글이 많이 달린 글
- 제안서를 문장 하나에 4-5줄글로 작성하는 정신나간 교수들
22 - 넌 의사소통이 안돼
17 - 대학원 재수에 대해 어떻게 생각하시나요?
15 - 교신저자의 기준?
12 - 워크샵 가는게 좋을까요?
11 - 과제없는 연구실
6 - 98년생 대학원 진학
6 - 국숭세단 학점 3.96 / SCIE 논문 1n편(졸업 기준) -카이스트 가능할까요?
9 - 미국대학 커미티에서 보는 한국 대학의 레벨
13 - 미국 반도체 공정/소자 랩 2년차 잡설
6 - 미국 PhD 가능성 있을까요...? (해외대 출신, 연구 경험 전무)
16 - 현지에서 연애
6 - 공무원 국비유학 관련 인데, 조언을 구합니다.
6

2025.11.30
2025.11.30
2025.12.03
대댓글 2개
2025.12.03
2025.12.04